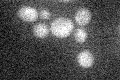
YGL208W
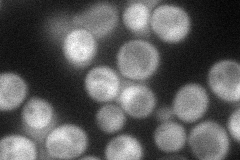
YGL208W
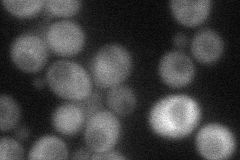
YGL208W
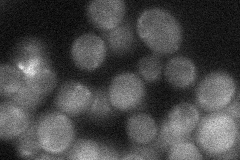
YGL208W

View description
One of three beta subunits of the Snf1 serine/threonine protein kinase complex involved in the response to glucose starvation; null mutants exhibit accelerated aging; N-myristoylprotein localized to the cytoplasm and the plasma membrane
Localization:
Intensity:
Fold change:
Significance:
-
C’ GFP library in SD
below threshold17.31 -
N' NOP1pr-GFP in SD
cytosol53.5043 -
N' TEF2pr-mCherry in SD
cytosol30.5158 -
N' NATIVEpr-GFP in SD
below threshold25.4688 -
N' TEF2pr-VC and Cyto-VN in SD

cytosol34.5322 -
C’ GFP library in SD+DTT

cytosol16.440.94No -
C’ GFP library in SD+H2O2

cytosol17.010.98No -
C’ GFP library in Starvation Media

cytosol13.910.8No -
C’ GFP library on the background of Pup2-DaMP

below threshold -
C’ GFP library on the background of CCT mutant

below threshold17.0820.986587No
